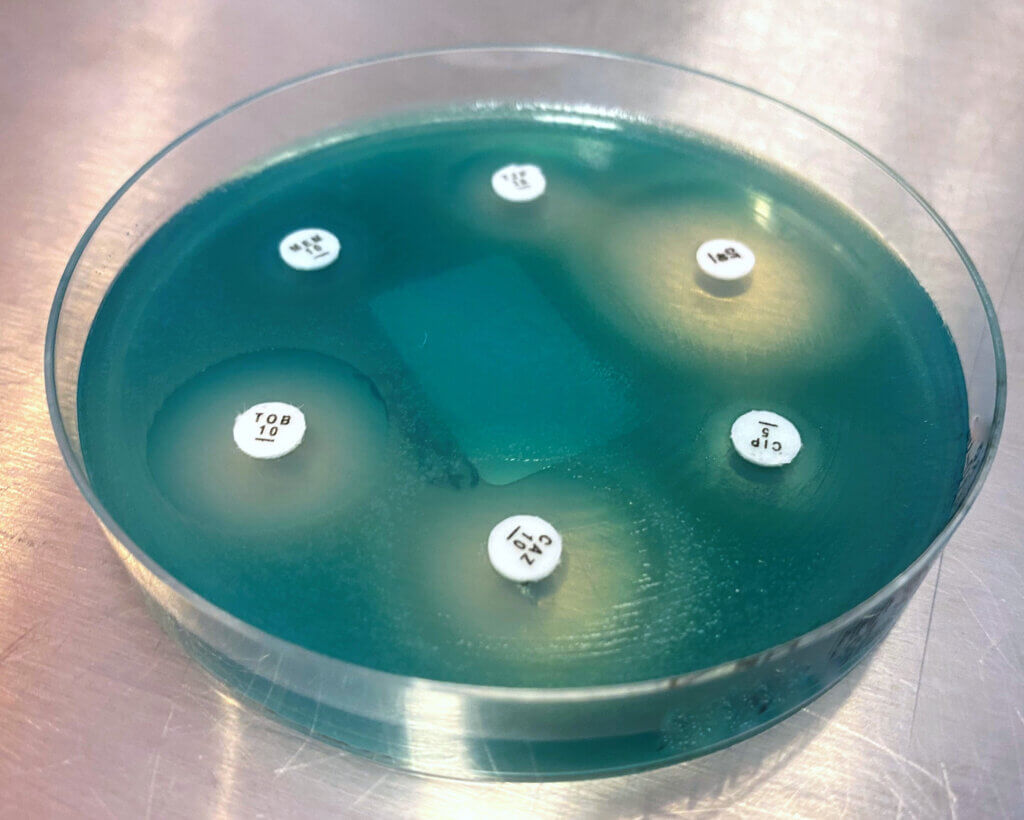

Het voorkomen van antibiotica-resistentie onder bacteriepopulaties is haast onmogelijk, maar initiatieven om nieuwe antibiotica of de juiste antibiotica in te zetten helpen wel de kans op resistente bacteriën te verlagen. Om de kans van slagen te vergroten grijpen verschillende onderzoekers naar artificiële intelligentie (AI). Amerikaanse onderzoekers kwamen met hun AI-methode tot 63 kanshebbers voor nieuwe antibiotica. En Rochelle Niemeijer van de start-up Nostics won de jaarlijkse Young Inventors Prize 2024 van het Europees Octrooi Bureau voor haar uitvinding van een draagbaar, op AI werkende testkit die snel de diagnose stelt en de juiste antibiotica aanwijst.
Steeds meer bacteriën zijn ongevoelig geworden voor veelgebruikte antibiotica, medicijnen die bacteriën doden of in hun groei remmen. Deze antibioticaresistentie is een gevaar voor mens en dier, en leidt jaarlijks wereldwijd tot 1,27 miljoen doden (volgens onderzoek in The Lancet, 2019) doordat er geen geschikt medicijn voorhanden is. Reden voor toenmalig minister Ark van Medische Zorg om in 2021 een aanpak tegen de antibioticaresistentie op te stellen. “Innovatie en onderzoek blijven belangrijk in het verminderen van het ontstaan van resistentie. Investeren in nieuwe antibiotica en alternatieve behandelstrategieën is noodzakelijk”, stelde Ark in de aanpak.

Enorme dataset analyseren met AI
Gelukkig werken onderzoekers stug door in het zoeken naar nieuwe antibiotica. Bijvoorbeeld de Amerikaanse onderzoekers van de Universiteit van Pennsylvania, die AI als hulpmiddel inzetten om op zoek te gaan naar kleine moleculen die ziekmakende microben kunnen doden of hun groei kunnen remmen, antimicrobiële peptiden genoemd. Zij zien AI als dé oplossing om nieuwe antibiotica te ontdekken. De onderzoekers analyseerden 87.920 genomen (DNA en RNA) van specifieke microben en 63.410 verzamelingen van microbiële genomen, ook wel ‘metagenomen’ genoemd, uit monsters afkomstig van verschillende omgevingen. Daar pasten ze machine learning op toe, een vorm van AI, waarbij de computer razendsnel enorm veel gegevens kan analyseren. Door de computer de juiste opdracht mee te geven, rolden er bijna 1 miljoen mogelijke, nieuwe antibiotica uit. “Wat voorheen jaren in beslag nam, kan nu binnen enkele uren worden volbracht met behulp van computers”, zegt onderzoeker Cesar de la Fuente-Nunez in het uitgebrachte persbericht. Bovendien waren deze peptiden in staat om zelfs de vorming van veelvoorkomende bacteriën in de darmen van de mens te remmen.
Sommige onderzoekers zien AI als dé oplossing tegen antibioticaresistentie.”
Peptiden als wapen
Veel bacteriën produceren kleine peptiden, ofwel eiwitten, waarmee ze continue andere bacteriën te lijf gaan door celmembranen te doorboren of celstructuren te vernietigen. Zelfs bacteriën van dezelfde soort vallen elkaar soms aan, om een bepaalde niche (leefomgeving) te bezetten. Als onderzoekers deze moleculen in handen weten te krijgen, kunnen we die gebruiken tegen bacterie-infecties. De onderzoekers van de Pennsylvania-studie hadden uiteindelijk, vanuit de eerste dataset van 1 miljoen, 100 van zulke peptiden gevonden in hun dataset. Ze testten deze peptiden vervolgens op hun antimicrobiële activiteit tegen bekende ziekmakende bacteriën als Escherichia coli, Klebsiella pneumoniae, Pseudomonas aeruginosa en Staphylococcus aureus. Bewust kozen de onderzoekers voor veelvoorkomende ziekmakers, waaronder ook enkele resistente bacteriestammen. “Bij de eerste test doodden 63 van de 100 kandidaten minstens één van de geteste bacteriën en soms zelfs meerdere,” vertelt mede-auteur Cesar de la Fuente-Nunez. “In sommige gevallen waren deze moleculen zelfs effectief tegen bacteriën bij een zeer lage doses.”
De microbiële genomen waren afkomstig van maar liefst 72 verschillende omgevingen, waarvan de meeste (36%) uit de bodem of van plantenmateriaal afkomstig waren, vanuit aquatische milieus (25%), of de menselijke darmen (13%). De meeste ontdekte peptiden zijn best zeldzaam in deze milieus, de menselijke darmen uitgezonderd.
Eerste behandelingen effectief
Behandeling met deze peptiden leverden bovendien vergelijkbare resultaten op als polymyxine B, een commercieel verkrijgbaar antibioticum dat wordt gebruikt voor de behandeling van aandoeningen zoals meningitis, longontsteking, sepsis en urineweginfecties. Helaas werd er geen peptide werd gevonden die in staat was om de beruchte MRSA (Methicillin-resistant Staphylococcus aureus)-bacterie, die vaak de kop opsteekt in ziekenhuizen, te doden.
Er is nog steeds een dagenlange wachttijd voordat een bacteriekweek laat zien om welke bacterie het gaat.”
Sneller diagnose stellen
In Nederland en daarbuiten werkt de start-up Nostics, onder andere gevestigd in Amsterdam, ook aan de inzet van AI maar in dit geval voor snel opsporen van de juiste antibiotica bij een bepaalde bacterie-infectie. Nostics streeft naar een snellere diagnose en behandeling van bacterie-infecties. Op dit moment moeten mensen 2 tot 3 dagen wachten voordat een bacteriekweek uitsluitsel geeft over de bacteriestam, en dus de benodigde antibiotica. Nostics wil direct bij het eerste consult uitsluitsel geven over de bacterie-infectie met een ontwikkelde testkit ofwel ´mini-laboratorium´. Ter plekke de diagnose kunnen stellen is vooral waardevol in afgelegen gebieden en voor mensen met lage inkomens, met beperkte toegang tot medische zorg.
Binnen 15 minuten uitslag
Op 9 juli 2024 kreeg CSO Rochelle Niemeijer de jaarlijkse Young Inventors Prize van het Europees Octrooi Bureau in handen, voor het eerste prototype van de testkit. De testkit kan een groot aantal ziekmakende bacteriestammen aantonen in bijvoorbeeld een urine- of bloedmonster. Op die manier kunnen veelvoorkomende urineweg- of bloedbaaninfecties snel worden opgespoord door artsen. Het innovatieve aan de methode is dat binnen 15 minuten duidelijk wordt om welke bacterie of schimmel het kan gaan. Op basis hiervan kan de arts bepalen wat de meest effectieve behandeling is. En dat is heel belangrijk, om het onjuiste gebruik van bestaande antibiotica tegen te gaan. “Om de werkzaamheid van bestaande antibiotica te behouden, moeten we ze op de juiste manier gebruiken. Ook om overmatig gebruik van medicatie tegen te gaan, en daarmee de gevaarlijke antibiotica-resistentie”, zegt Niemeijer. “Onze test is ontwikkeld om dat mogelijk te maken.” Het bedrijf werkt eerst aan de inzet van de testkit voor urineweginfecties, later zal het ook geschikt zijn voor het diagnosticeren van bloedbaaninfecties, soas en schimmelinfecties.
Dit artikel is exclusief voor abonnees
Log in of abonneer om verder te lezen.












